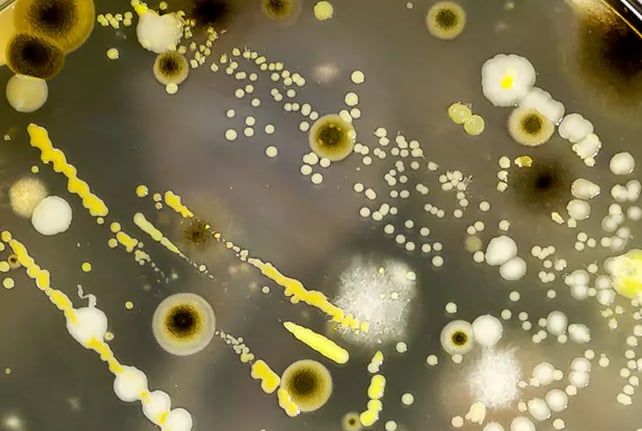
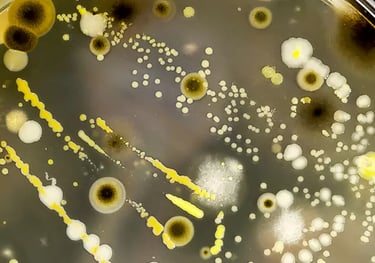

Sanger Sequencing
and related services
At C SIX Labs, we offer reliable and accurate Sanger Sequencing services, ideal for a wide range of molecular biology applications. Our advanced sequencing platform delivers high-quality reads for diverse sample types, supporting both research and clinical diagnostics.
We specialize in the sequencing of PCR products, providing fast turnaround and clear chromatograms. Our service includes microbial identification using 16S/18S/ITS sequencing to help you accurately classify bacteria, fungi, and other microorganisms. For ecological and biodiversity studies, our DNA barcoding service enables species-level identification across various life forms with precision.
Our team also supports primer walking, allowing you to sequence longer DNA fragments beyond traditional read lengths. In addition, we offer fragment analysis, including microsatellite genotyping, useful for population genetics, mutation detection, and forensic applications.
With expert technical support and strict quality control, we ensure dependable results for every project. Whether you're conducting routine sequencing or need custom solutions, our services are designed to meet your specific research goals.
Partner with C SIX Labs for trusted Sanger sequencing and DNA analysis that delivers insight, accuracy, and efficiency.


Sequencing of PCR Products
We provide accurate and high-quality sequencing of PCR-amplified DNA fragments.
Microbial Identification
We offer precise microbial identification through 16S rRNA, 18S rRNA, or ITS region sequencing.

DNA Barcoding
Quick and accurate species identification using standard genetic markers.
Primer Walking
A method to sequence long DNA regions by designing successive primers along the template.
Fragment Analysis
High-resolution sizing of DNA fragments for microsatellite genotyping, mutation detection, and genetic diversity studies.




Menu
© 2025. All rights reserved.


Locations
C- six labs pvt ltd
Ground Floor, No. 42, Jayanagar,
Chandranagar PO
Palakkad-678007, Kerala
C- six labs pvt ltd
Plot# 48/A, Glass Factory road, 2nd cross, Ananth Nagar phase-2, Electronic city. Bengaluru560100
Contact Us
Phone : 8714826667 / 9663155991
